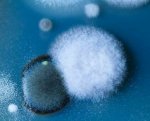
20210612_165650.jpg

-
Форум доступен на основном домене:
временно не доступен olymprc.biz
olymprc.com
И также в TOR сети по ссылке:
olymp3z5tdjywb2piewcrqqtrtmkgexhrzpytnq2vuli5dpjdu764wyd.onion
Если основной домен не доступен, то можете использовать зеркала:
olymprc54rbqyfv3ddr2jwdqzvrayed7zg4d7izvm6sreha5ax6wtwyd.onion
olymp4e74mzx74pz5tzryfr7slh3azefmu4cchg5vzoqzeqovuvj6gid.onion
⚠️ Факты и аргументы , но не факт ....но аргумент железный.📜
- Автор темы JOUR
- Дата начала
А знаете ли вы, что происходит с пирамидами?
Все пирамиды Египта медленно, но верно «тают». Например, сегодня от изначальной высоты пирамиды Хеопса – 146 м 60 см – осталось только 138,75. И все-таки, несмотря на безжалостное время, это сооружение считается одним из самых грандиозных за всю историю человеческой цивилизации. Не случайно оно входит в семь чудес света.
Все пирамиды Египта медленно, но верно «тают». Например, сегодня от изначальной высоты пирамиды Хеопса – 146 м 60 см – осталось только 138,75. И все-таки, несмотря на безжалостное время, это сооружение считается одним из самых грандиозных за всю историю человеческой цивилизации. Не случайно оно входит в семь чудес света.
Принудительный боди-позитив в Мавритании
Мавританцы без ума от полных женщин, благо, у них большой выбор. Для подготовки к свадьбе семьи девушек начинают принудительное кормление — в день будущей невесте полагается съедать 16 000 калорий. Ритуал начинается задолго до свадьбы и может длиться несколько лет.
Для справки:
дневная норма атлета по силовому экстриму — 6-8 тысяч калорий в день.
Мавританцы без ума от полных женщин, благо, у них большой выбор. Для подготовки к свадьбе семьи девушек начинают принудительное кормление — в день будущей невесте полагается съедать 16 000 калорий. Ритуал начинается задолго до свадьбы и может длиться несколько лет.
Для справки:
дневная норма атлета по силовому экстриму — 6-8 тысяч калорий в день.